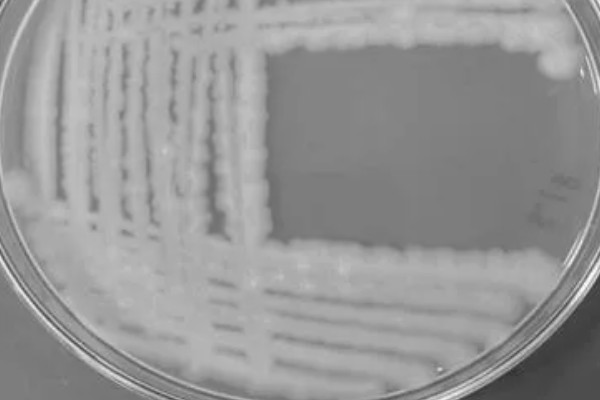
脱氧雪腐镰刀菌烯醇的副作用，会导致动物食欲下降、体重减轻等
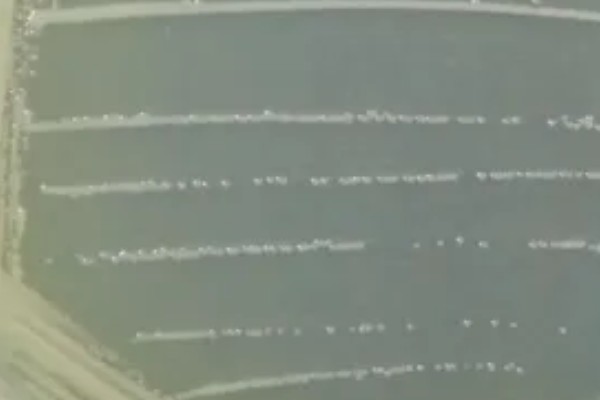
脱氧雪腐镰刀菌烯醇的副作用，会导致动物食欲下降、体重减轻等

1、对动物的副作用:主要表现为食欲下降、体重减轻、代谢紊乱等。摄入量较大时,会引起呕吐。
2、对人体的副作用:主要表现为头昏、腹胀、恶心、呕吐等。摄入量过大时,会导致体温、脉搏、血压升高。

一、脱氧雪腐镰刀菌烯醇的副作用
1、对动物的副作用(毒性):导致动物的食欲下降、体重减轻、代谢紊乱等,如果摄入量较多,则还会引发呕吐。
2、对人体的副作用(毒性):使人出现头昏、腹胀、恶心、呕吐等症状,如果摄入量较多,则会使人的脉搏、体温以及血压略有升高。
二、氯前列醇钠对母猪的作用与用法
1、作用:可促使母猪黄体迅速消退且抑制其分泌,对不发情母猪有催情作用,治疗子宫疾病,诱导母猪在白天产仔。

2、用法:治疗子宫疾病在母猪产后第二天注射氯前0.2mg,诱导白天产仔在分娩前1-2天的上午8-10点注射氯前2支。
声明:本文由作者上传并发布,农服务网仅提供信息发布平台,文章仅代表作者个人观点,不代表农服务网立场,内容旨在传播知识,若有内容错误或侵权等问题请及时与本网站联系,我们将在第一时间作更正或删除处理。